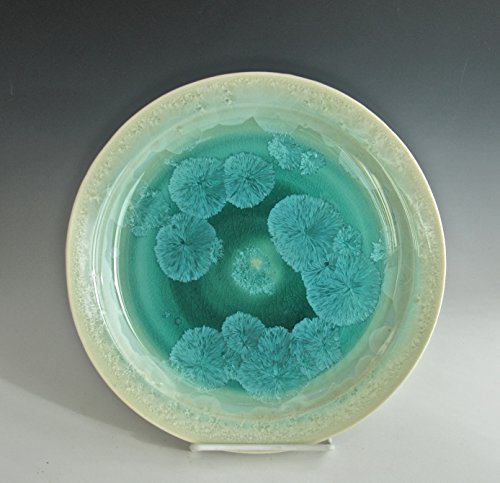

I threw this plate on the wheel, trimmed it and then finished it in a Crystalline firing described below. Crystalline glazing is a particularly beautiful but equally involved process. The pieces are brought to a high temperature quickly in the kiln and then soaked at a slightly lower temperature to allow for the special crystals to form from the zinc in the glaze. A special "pedastal" must be made for each piece to catch the glaze as it runs down the vase. Then the pot must be carefully (the piece can be easily broken at this point) separated from the pedastal and then the foot is ground smooth. Each piece has magical crystals and is totally unique! 10 3/4" by 1 1/8"
Trustpilot
1 month ago
1 week ago